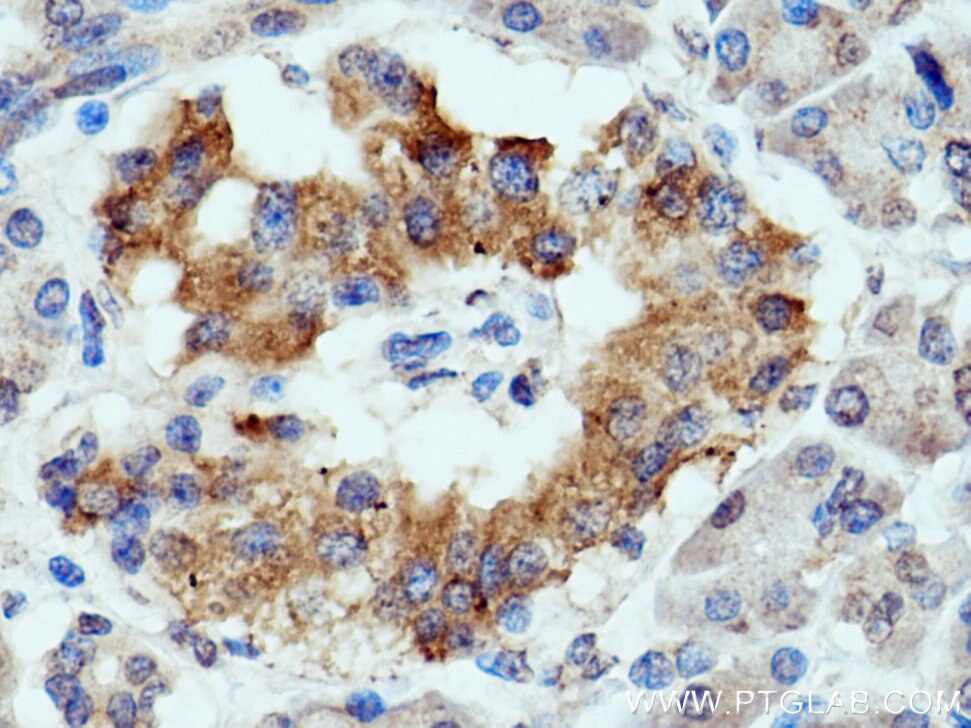
Immunohistochemistry (IHC) staining of human pancreas cancer tissue using MUC5AC Polyclonal antibody (20725-1-AP)

Tested Applications
| Positive IHC detected in | human stomach tissue, human pancreas cancer tissue Note: suggested antigen retrieval with TE buffer pH 9.0; (*) Alternatively, antigen retrieval may be performed with citrate buffer pH 6.0 |
Recommended dilution
| Application | Dilution |
|---|---|
| Immunohistochemistry (IHC) | IHC : 1:400-1:1600 |
| It is recommended that this reagent should be titrated in each testing system to obtain optimal results. | |
| Sample-dependent, Check data in validation data gallery. | |
Published Applications
| WB | See 1 publications below |
| IHC | See 2 publications below |
Product Information
20725-1-AP targets MUC5AC in WB, IHC, ELISA applications and shows reactivity with human samples.
| Tested Reactivity | human |
| Cited Reactivity | human, mouse |
| Host / Isotype | Rabbit / IgG |
| Class | Polyclonal |
| Type | Antibody |
| Immunogen |
Peptide Predict reactive species |
| Full Name | mucin 5AC, oligomeric mucus/gel-forming |
| Calculated Molecular Weight | 527 kDa |
| GenBank Accession Number | NM_017511 |
| Gene Symbol | MUC5AC |
| Gene ID (NCBI) | 4586 |
| RRID | AB_3669342 |
| Conjugate | Unconjugated |
| Form | Liquid |
| Purification Method | Antigen affinity purification |
| UNIPROT ID | P98088 |
| Storage Buffer | PBS with 0.02% sodium azide and 50% glycerol, pH 7.3. |
| Storage Conditions | Store at -20°C. Stable for one year after shipment. Aliquoting is unnecessary for -20oC storage. 20ul sizes contain 0.1% BSA. |
Background Information
MUC5AC is a member of the mucin family, a heterogeneous group of 21 abundant, high molecular weight O-glycoproteins that can be either secreted or membrane bound. Multiple cysteine-rich domains in both N- and C-terminal regions of MUC5AC are responsible for its disulfide-mediated polymerization, which is critical for gel-forming properties. (PMID: 26751774, PMID: 27845339)
Protocols
| Product Specific Protocols | |
|---|---|
| IHC protocol for MUC5AC antibody 20725-1-AP | Download protocol |
| Standard Protocols | |
|---|---|
| Click here to view our Standard Protocols |
Publications
| Species | Application | Title |
|---|---|---|
Int Immunopharmacol Corynebacterium striatum drives neutrophilic asthma via IL-17 signaling activation | ||
Front Pediatr Comparison of clinical manifestations and immunoreactivities of Meckel's diverticulum with and without gastric heteroplasia | ||
Int Immunopharmacol Dietary choline deficiency potentiates Helicobacter pylori-driven gut-liver dysfunction via microbial metabolic rewiring | ||
Mol Immunol Knockdown of Brg1 reduced mucus secretion in HDM stimulated airway inflammation |